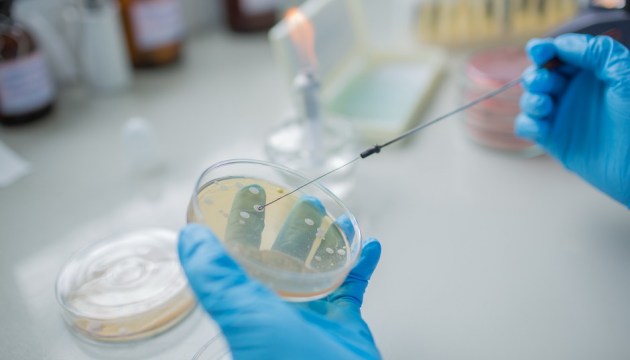
��������� ������� �������� �������� E.coli: ��� �������� �� ������ ������

Чтобы выявить продукты питания, ставшие причиной кишечных инфекций, вызванных бактериями E.Coli, продуцирующими токсин Шига/Веротоксигенные бактерии, Продовольственно-ветеринарная служба (ПВС) проводит проверки как в дошкольных учреждениях, которые посещают заболевшие дети, так и в пунктах питания, сообщает Служба.
Проверки проведены в 15 дошкольных учреждениях и 10 торговых точках. На данный момент на лабораторные исследования направлено 53 пробы пищевых продуктов (в том числе 15 проб, взятых в торговых заведениях) и 106 проб смывов с поверхностей, взятых в дошкольных учреждениях.
Результаты лабораторных исследований ожидаются не ранее следующей недели, но вполне вероятно, что они могут занять больше времени.
Пока тестирование не дало информации о возможном возбудителе заболевания.
Напомним, что Центр профилактики и контроля заболеваний проводит эпидемиологические расследования для выявления источников инфекции.
Управление продовольствия и ветеринарии напоминает, что для защиты от болезней пищевого происхождения необходимо соблюдать личную гигиену - мыть руки до и после обработки сырых продуктов, а также соблюдать гигиену на кухне.
Сырые продукты животного происхождения - мясо, рыба, яйца - должны быть перед употреблением термически обработаны.
Для работы с сырыми продуктами необходимо использовать отдельный кухонный инвентарь - разделочную доску, нож, посуду.
Готовые продукты или продукты, которые не будут термически обрабатываться, не должны контактировать с сырыми продуктами!
Поверхности и руки после обработки сырых продуктов должны быть тщательно вымыты.
Напомним: согласно данным Центра профилактики и контроля заболеваний (SPKC), число контактных лиц, выявленных в ходе эпидемиологического расследования вспышки инфекции, вызванной опасной кишечной палочкой, достигло 212-и. Стало известно о еще одном заболевшем ребенке.
В настоящее время эпидемиологи продолжают работу по установлению всех контактных лиц. Как подтвердили в SPKC, на сегодняшний день получены уведомления о 22 случаях инфекции, вызванной энтерогеморрагической кишечной палочкой E.coli — заразились 18 детей и двое взрослых.